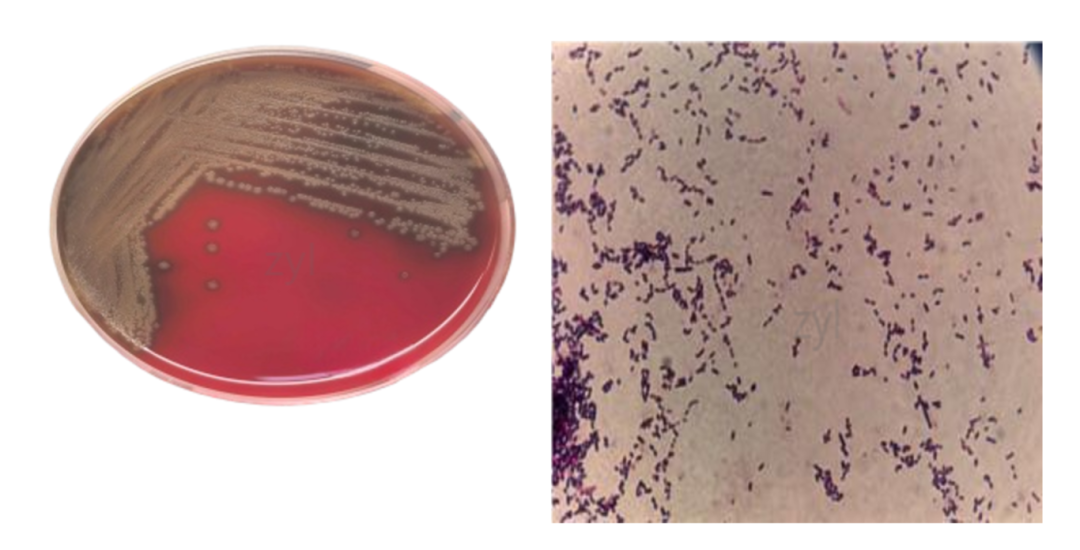

赵阿姨最近遇到件烦心事:左眼下面肿了个包,不停流出黄白色脓液,还带着血丝。去医院检查后,医生告诉她这是“泪囊炎”,而罪魁祸首竟然是一种口腔里的常见细菌!
一、藏在嘴里的"潜伏者"
我们每个人的口腔里都生活着数百种细菌,其中一种叫口腔链球菌的细菌最为常见。它平时安分守己,但当人体抵抗力下降时(比如感冒、疲劳),就可能趁虚而入。甚至是我们不经意间的一些小动作,比如用手接触口腔后又揉眼睛,就可能让细菌沿着一条“隐形通道”悄悄潜入眼睛。
具体来说,口腔链球菌从口腔到达眼睛的路径非常典型:首先,它们可能在我们咳嗽、打喷嚏,或者用手接触口腔、鼻腔分泌物时,附着在手上。如果此时没有彻底洗手就揉眼睛,细菌便会突破泪液的防御,侵入眼表。更隐蔽的一条路径是,它们还可以利用我们头面部天然相通的“暗道”——比如从口腔经鼻泪管逆行而上。我们的眼泪原本应该通过一条“管道”(泪道)排入鼻腔,而当人抵抗力下降、眼部防御能力减弱时,这条通道也可能成为细菌反向运动的捷径。一旦这条通道功能失调或发生堵塞,细菌就会在眼睛里“安家落户”,并大量繁殖,从而引发感染。
二、感染后的典型表现
如果您的眼睛出现以下症状,要警惕可能是细菌感染:
1.持续性流泪,无情绪波动或外界刺激时仍流泪不止,遇风加重
2.分泌物增多,眼角常有粘性或脓性分泌物,擦拭后反复出现。
3.泪囊区皮肤红肿,触之结实、压痛。
4.眼角皮肤糜烂、肿胀,甚至出现发热

三、医生如何找到并惩治“真凶”?
第一步,医生取样:医生会用无菌棉签取少量脓液送检验科检测
第二步,细菌培养/鉴定:检验科工作人员用多种培养基进行细菌培养(图1)
第三步,药物敏感性检测:找出最能消灭这种细菌的抗生素("以毒攻毒"的精准匹配)
图:口腔链球菌菌落及镜下形态
四、预防小贴士
知道了致病原因,预防起来也有了针对性。首先,我们要改掉揉眼习惯,避免细菌搭“顺风车”进入眼睛;平时注重手部卫生,饭前便后要洗手;若受到了眼部外伤要及时就医
医生提醒:如果眼红持续3天以上,或出现视力模糊等情况,请立即就医!
现在,让我们回到文章开头的故事:赵阿姨从8月6日开始在医院接受治疗。医生在将样品送至检验科检验的同时,根据临床经验,给她用了一种叫头孢曲松的抗生素,这是为了防止在等待检验结果期间感染加重。2-3天后,化验结果出来了,发现是一种叫口腔链球菌的细菌在作怪。而药物测试结果显示,现在用的头孢曲松对这种细菌就很有效,这说明医生一开始的选择是对的,可以继续用药。等到一周后再次检查时,已经检测不到细菌了,说明药物起了作用。不过赵阿姨眼角处还是有点脓泡,所以医生建议继续用现在的药,同时每天帮她把脓液清理干净,直至赵阿姨彻底康复。
眼睛的健康需要我们时刻守护,口腔链球菌这类“潜伏者”的存在,也提醒着我们健康无小事。很多时候,看似不相关的身体部位,也可能通过细菌传播产生关联,一个不经意的揉眼动作,就可能引发不必要的感染。养成良好的卫生习惯、关注身体的细微信号、及时寻求专业医疗帮助,这三点正是抵御此类感染的关键。希望赵阿姨的经历能给大家带来启发,从日常小事做起,做好健康防护,让眼睛远离红肿流脓的困扰,始终保持清澈明亮。


